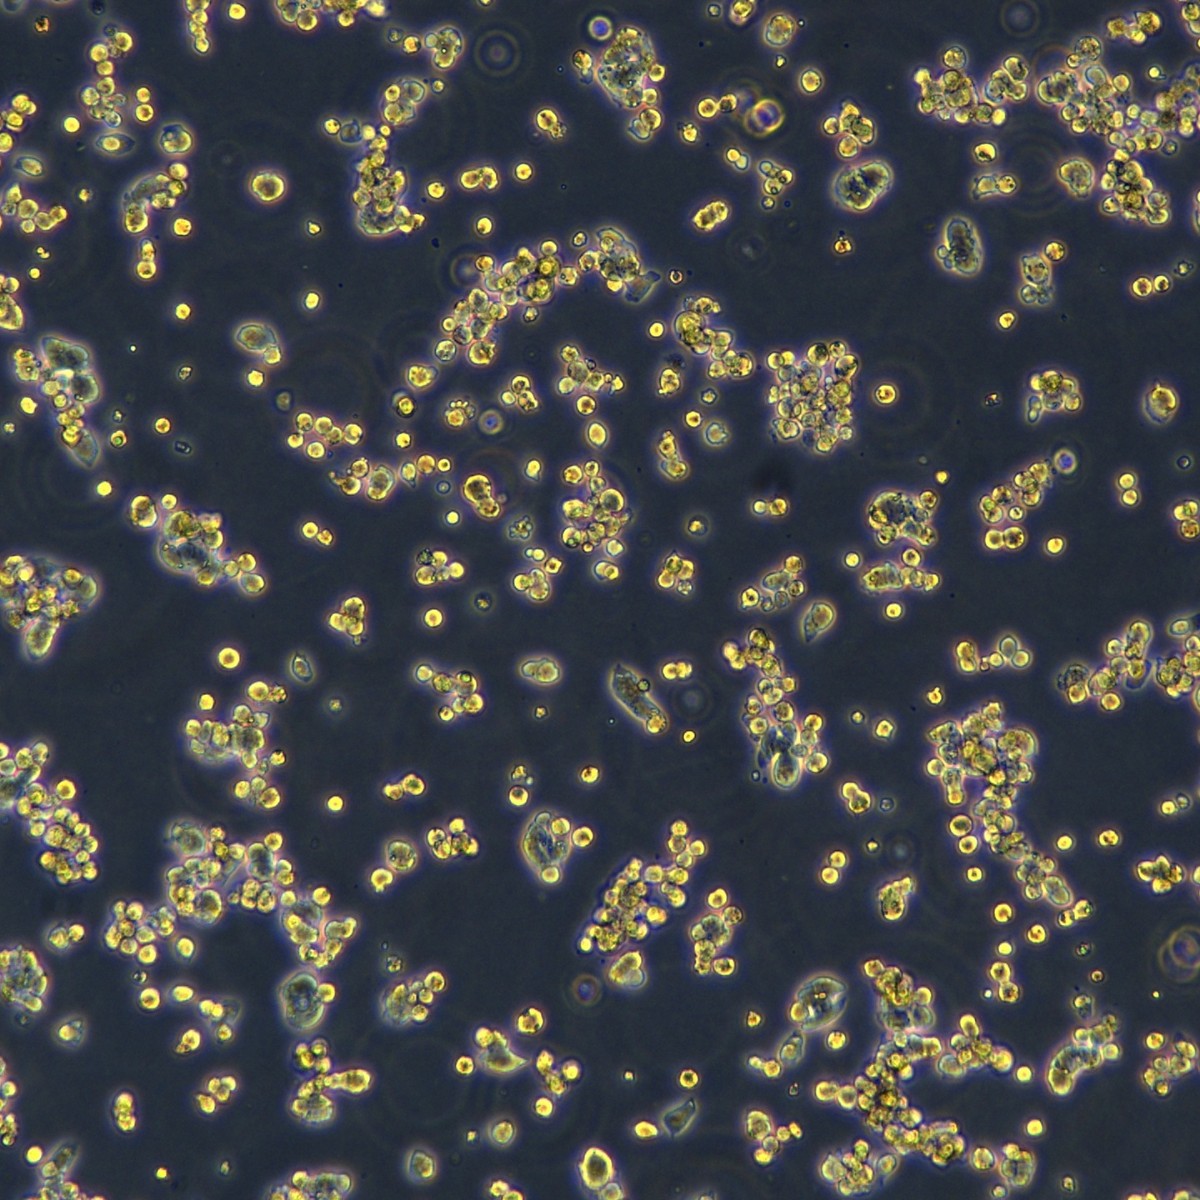
Meisen Ctcc Meisen рак печени человека, штам, устойчивый к сорафенибу Hepg2/Sorafenib

Клеточная биология
Фильтр
Ценовой диапазон (CNY)
-
Поиск в категории
Подходит для возраста чтения
Импортировать или нет
уровень
уровень
Категория
Товары (443)
Сортировка:

Оптовая продажа экзосомного клеточного раствора, высококонцентрированный гранулированный экстракт овечьей плаценты, осветление, против потемнения, выравнивание тона кожи
68.00 CNY / ≈ 820 ₽
Мин. заказ: 1 шт
Продажи: 2 Повтор: 0%

Ca1633 набор для определения активности клеток и цитотоксичности Calcein/Pi, красные кровяные клетки, мертвые клетки
500.00 CNY / ≈ 6 031 ₽
Мин. заказ: 1 шт
Продажи: 1 Повтор: 0%

Оптовая продажа сырьевых материалов для медицинской косметики, экзосомный клеточный раствор для заполнения и тонкой настройки кожи, представленный в салонах красоты
128.00 CNY / ≈ 1 544 ₽
Мин. заказ: 1 шт
Повтор: 0%

500 миллионов активных экзосомных клеточных растворов, высококонцентрированные частицы для восстановления основы кожи, высокоувлажняющие и интенсивно увлажняющие сырьевые материалы оптом
38.00 CNY / ≈ 458 ₽
Мин. заказ: 1 шт
Повтор: 0%

Раствор клеточного запаса экстрацеллюлярных везикул для больничного использования, экстракт овечьей плаценты, сырьё, увлажняющее, против морщин, подтягивающее, увлажняющая эссенция экстрацеллюлярных везикул
1000.00 CNY / ≈ 12 061 ₽
Мин. заказ: 1 шт
Повтор: 0%

Сmoothing и укрепляющее лечение шейных морщин в салоне красоты с высококонцентрированными экстрацеллюлярными везикулами сырьевых материалов оптом
500.00 CNY / ≈ 6 031 ₽
Мин. заказ: 1 шт
Повтор: 0%

Экзосомные клетки овечьей плаценты сырьевые материалы оптом, осветляющая, увлажняющая, сияющая, гидратирующая эссенция, оригинальный раствор медицинского качества
280.00 CNY / ≈ 3 377 ₽
Мин. заказ: 1 шт
Продажи: 1 Повтор: 0% Рейтинг: 5.0

Раствор для клеточной культуры экзосом, гидролизат экстракта овечьей плаценты, кератин, питает кожу головы и защищает линию волос, оптовые сырьевые материалы
2800.00 CNY / ≈ 33 771 ₽
Мин. заказ: 1 шт
Повтор: 0%

Meisenctcc Meisen шейная аденокарцинома человека, штам, устойчивый к цисплатину Hela S3/Ddp
12000.00 CNY / ≈ 144 733 ₽
Мин. заказ: 1 шт
Повтор: 0%

Биологические реагенты R&D поставка биологических клеточных сырьевых материалов по запросу
2.50 CNY / ≈ 30 ₽
Мин. заказ: 100 шт
Продажи: 5880 Повтор: 50%

B23317 набор для скрининга фрагментов нуклеиновых кислот Beckman 5ml лаборатория Beckman Spriselect
4187.00 CNY / ≈ 50 500 ₽
Мин. заказ: 1 шт
Повтор: 0%

A63881 набор для очистки нуклеиновых кислот Beckman 60ml лабораторный реагент Beckman Ampure Xp
15146.00 CNY / ≈ 182 678 ₽
Мин. заказ: 1 шт
Повтор: 0%

Meisen Ctcc Meisen оральный плоскоклеточный штам, устойчивый к паклитакселу Wsu-Hn30/Taxol
12000.00 CNY / ≈ 144 733 ₽
Мин. заказ: 1 шт
Повтор: 0%

Meisen Ctcc Meisen яичниковая аденокарцинома ясноклеточного типа, штам, устойчивый к цисплатину Es-2/Ddp
6800.00 CNY / ≈ 82 016 ₽
Мин. заказ: 1 шт
Повтор: 0%

Meisenctcc человеческий желчный проток/рак, штам, устойчивый к флуороурацилу Rbe/5-Fu
6800.00 CNY / ≈ 82 016 ₽
Мин. заказ: 1 шт
Повтор: 0%

Meisen Ctcc Meisen рак печени человека, штам, устойчивый к сорафенибу Hepg2/Sorafenib
6800.00 CNY / ≈ 82 016 ₽
Мин. заказ: 1 шт
Повтор: 0%

A58481 набор для электрофорезного разделения Beckman Cief Peptide Marker Kit
15201.00 CNY / ≈ 183 341 ₽
Мин. заказ: 1 шт
Повтор: 0%

Meisen Ctcc Meisen рак желудка человека, штам, устойчивый к оксалиплатину Mkn-45/Oxaliplatin
12000.00 CNY / ≈ 144 733 ₽
Мин. заказ: 1 шт
Повтор: 0%

Meisen Ctcc Meisen рак толстой кишки, штам, устойчивый к онвансертибу Sw620/Onvansertib
12000.00 CNY / ≈ 144 733 ₽
Мин. заказ: 1 шт
Повтор: 0%

Meisenctcc человеческая ясноклеточная аденокарцинома почки, штам, устойчивый к сорафенибу 786-0/Sorafeni
6800.00 CNY / ≈ 82 016 ₽
Мин. заказ: 1 шт
Повтор: 0%

Meisen Ctcc человеческая аденокарцинома яичников, штам, устойчивый к цисплатину Sk-Ov-3/Ddp
6800.00 CNY / ≈ 82 016 ₽
Мин. заказ: 1 шт
Повтор: 0%

Meisen Ctcc хронический миелоидный лейкоз, штам, устойчивый к иматинибу K562/Imatinib
12000.00 CNY / ≈ 144 733 ₽
Мин. заказ: 1 шт
Повтор: 0%

Meisenctcc Meisen человеческий лейкоз, штам, устойчивый к доксорубицину K562/Adr
12000.00 CNY / ≈ 144 733 ₽
Мин. заказ: 1 шт
Повтор: 0%

Meisen Ctcc Meisen рак толстой кишки, штам, устойчивый к флуороурацилу Hct8/5-Fu
12000.00 CNY / ≈ 144 733 ₽
Мин. заказ: 1 шт
Повтор: 0%

Meisen Ctcc Meisen аденокарцинома почки человека, штам, устойчивый к сорафенибу Achn/Sorafenib
6800.00 CNY / ≈ 82 016 ₽
Мин. заказ: 1 шт
Повтор: 0%

Meisenctcc человеческая аденокарцинома яичников, штам, устойчивый к цисплатину Caov-3/Ddp
6800.00 CNY / ≈ 82 016 ₽
Мин. заказ: 1 шт
Повтор: 0%

Meisenctcc Meisen ороговевшая карцинома орофарингеальной области, штам, устойчивый к цисплатину Fadu/Ddp
12000.00 CNY / ≈ 144 733 ₽
Мин. заказ: 1 шт
Повтор: 0%

Meisenctcc мышиные меланомные клетки B16F10-Ova
4800.00 CNY / ≈ 57 893 ₽
Мин. заказ: 1 шт
Повтор: 0%

Meisenctcc человеческие эмбриональные почечные клетки Hek293
2000.00 CNY / ≈ 24 122 ₽
Мин. заказ: 1 шт
Повтор: 0%

Meisen Ctcc клетки рака печени человека Snu886
6500.00 CNY / ≈ 78 397 ₽
Мин. заказ: 1 шт
Повтор: 0%

Meisen Ctcc Meisen клетки низкодифференцированной аденокарциномы легких человека Sk-Lu-1
2600.00 CNY / ≈ 31 359 ₽
Мин. заказ: 1 шт
Повтор: 0%
Клетки множественной миеломы Meisen Ctcc Rpmi-8226
2000.00 CNY / ≈ 24 122 ₽
Мин. заказ: 1 шт
Повтор: 0%
Кэш: 15920 категорий |
Обновлено: 29.10.2025, 15:15:08